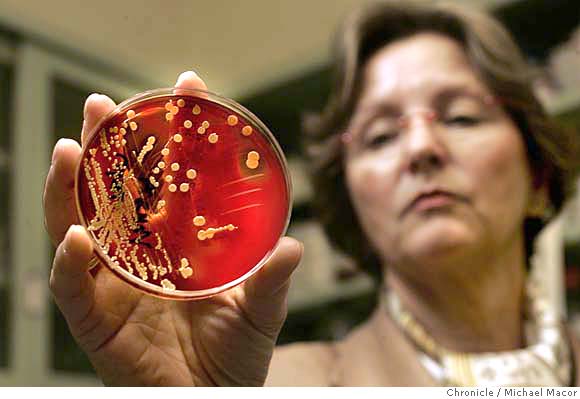

![]()
El estafilococo feroz
autores: Jesús Mingorance y José Ramón Paño (Hospital Universitario La Paz)
El estafilococo identificado. La Dra. Francoise Perdreau-Remington, directora del laboratorio de Epidemiología Molecular del Hospital General de San Francisco muestra una placa con estafilocco. Foto: Michael Macor
.
Desde el punto de vista genético, S. aureus es un microorganismo altamente clonal. Como además tiene una gran capacidad de dispersión, la mayoría de los aislados clínicos pertenecen a un puñado de linajes, o clones, de distribución mundial que se parecen mucho entre sí, aunque difieren en el contenido en genes de virulencia y resistencias a antibióticos. Estas diferencias son importantes porque determinan tanto la agresividad de la infección como su susceptibilidad al tratamiento.

Staphylococcus aureus. Foto: Rocky Mountain Laboratories.
MRSA: Staphylococcus aureus resistentes a meticilina
Ya en 1948 se detectaron los primeros casos de infecciones por estafilococos portadores de penicilinasa, y por tanto resistentes a la penicilina. En 1961, apenas tres años después de la introducción en la clínica de la meticilina, una variante de la penicilina resistente a las penicilinasas, se describen los primeros casos de cepas resistentes a estos nuevos antibióticos. Desde entonces, estas cepas de S. aureus resistentes a meticilina (abreviado SARM, aunque se utiliza más comunmente el inglés MRSA), se han ido extendiendo por todo el mundo y en algunos países constituyen una fracción importante de todos los aislados clínicos. La resistencia a meticilina la confiere el gen mec, que codifica para una proteína fijadora de penicilina, PBP2a. La proteína PBP2 de S. aureus participa en la síntesis de la pared celular, actividad que en esta bacteria está asociada tanto al crecimiento como a la división celular. Los antibióticos de la familia de los betalactámicos se parecen estructuralmente al sustrato de las PBPs, y se unen a ellas ináctivándolas de manera irreversible. La proteína PBP2a tiene baja afinidad por el antibiótico, y por tanto se mantiene activa en presencia de las dosis que pueden emplearse en la práctica clínica. La expansión de los MRSA desde mediados del siglo XX es un fenómeno sorprendente, no sólo por su rapidez, sino porque se trata en realidad de una serie de ondas epidémicas superpuestas. Se conocen en este momento dos grandes grupos de cepas MRSA que corresponden a líneas evolutivas diferentes pero que parecen estar confluyendo en la actualidad.
HA-MRSA: patógenos relacionados con el ámbito sanitario
Los primeros casos de MRSA se describieron en la década de los sesenta, y eran en su mayoría brotes e infecciones hospitalarias (de ahí el acrónimo HA-MRSA, por hospital-acquired-MRSA). La proporción de estafilococos resistentes frente a los sensibles a meticilina ha ido aumentando con los años, llegando a ser en España un 20-30 % de los aislados clínicos. De forma paralela se ha ido ampliando el entorno en el que se producen las infecciones, y actualmente no se les considera patógenos exclusivamente hospitalarios, sino de forma más general, relacionados con el ámbito sanitario. La definición oficial de HA-MRSA incluye a todos aquellos aislados obtenidos de pacientes que tienen contacto habitual ó reciente (en un período inferior a un año) con hospitales u otras instituciones sanitarias (residencias, centros de diálisis, etc.).
Los HA-MRSA suelen ser responsables de neumonías, infecciones de heridas quirúrgicas, e infecciones asociadas al uso de catéteres. Suelen llevar asociadas resistencias a otros antibióticos, en concordancia con el paradigma de las multirresistencias que establece que son seleccionadas por la tremenda presión antibiótica que se ejerce en los hospitales, y en el ámbito sanitario en general. La multirresistencia es un problema grave porque limita fuertemente las opciones terapeúticas, aunque en el caso del MRSA suelen quedar opciones disponibles como la vancomicina ó el linezolid.
CA-MRSA: el estafilococo feroz
En 1993 se describieron los primeros casos de MRSA no asociados al ámbito sanitario. Los CA-MRSA (de community-acquired MRSA, MRSA adquiridos en el ámbito comunitario) se han extendido desde entonces por todo el mundo. Se manifiestan en brotes epidémicos locales, pero también se dan casos aislados, que habitualmente producen infecciones de piel sin muchas complicaiones. Con cierta frecuencia pueden resultar en infecciones más graves: neumonías necrotizantes, osteomielitis, endocarditis, etc. No suelen llevar asociadas resistencias a otros antibióticos y se caracterizan por ser muy virulentos. Uno de los clones más agresivos es el USA300, que se ha extendido en los últimos años por los Estados Unidos, y ha sido descrito ya en Europa en varias ocasiones. El riesgo de infección por USA300 es mayor entre los hombres homosexuales sexualmente activos, por ello ha sido presentado por algunos medios de comunicación como el SIDA del siglo XXI ó la nueva epidemia de los homosexuales. Sin embargo, la infección no se limita, ni mucho menos, a la población homosexual, puede afectar a cualquier persona, y recientemente ha entrado en el ámbito sanitario, siendo ya responsable de diversos brotes epidémicos hospitalarios en Estados Unidos. La aparición de brotes hospitalarios producidos por CA-MRSA distintos al USA300 ha sido descrita en varias ocasiones en diversos lugares de todo el mundo, y parece indicar que los CA-MRSA se están introduciendo en el ámbito sanitario.
Los análisis genéticos muestran que USA300 es un grupo clonal, es decir, todos los aislados provienen de un ancestro común. Sin embargo, no es el único clon de CA-MRSA, varios análisis realizados con aislados de todo el mundo muestran que existen diversos clones de CA-MRSA, y que han surgido de manera independiente en repetidas ocasiones.
La evolución del estafilococo feroz
La evolución de los CA-MRSA es un tanto enigmática. Los diversos clones se han originado de manera independiente, y lo han hecho fuera del ámbito sanitario, donde la presión antibiótica es baja. Esto sugiere que los CA-MRSA han surgido en respuesta a un modo de selección puntual. Si los CA-MRSA tienen mayor transmisibilidad ó capacidad de dispersión que el resto de los estafilococos, como sugiere la rapidez con la que se han extendido por todo el mundo, la selección local y limitada en el tiempo que se produce cuando una persona recibe un tratamiento antibiótico podría ser suficiente para mantener el gen de resistencia en la población, incluso si, como es el caso, la mayoría de los portadores no están tomando antibióticos. No hay que olvidar que el 80% del consumo total de antibióticos se produce fuera del ámbito hospitalario, y que, aunque globalmente la presión antibiótica en el medio comunitario sea baja, existen en todo momento una gran cantidad de individuos recibiendo tratamientos antibióticos por diversas infecciones, que actuarían como puntos de selección y amplificación de la población MRSA. Este fenómeno de “selección puntual y adaptación global” sería análogo a los procesos de selección periódica estudiados ampliamente por los genetistas, y aunque destaca por la rapidez con la que se ha producido la dispersión geográfica hasta alcanzar el nivel de pandemia y por la gravedad de las infecciones que puede producir, no es un fenómeno exclusivo del estafilococo. Otras bacterias en las que se han seleccionado resistencias a antibióticos en el ámbito comunitario son el neumococo (Streptococcus pneumoniae) resistente a betalactámicos, ó la Shigella multirresistente. No conocemos cuales son los factores que determinan la selección de un microorganismo y no de otro, ó qué antibióticos y en qué cantidades favorecen la selección de unas u otras resistencias en la comunidad. Estas son, sin duda, cuestiones difíciles de estudiar pero que deben abordarse si queremos llegar a comprender por qué se extienden las resistencias a antibióticos.
GLOSARIO

Me gustaría recibir información sobre un caso en particular: una hermana llegó a un hospital con 32 semanas de embarazo y una tromboflebitis en el muslo derecho. Estando hospitalizada le hicieron cesárea para tener a su bebé y 8 días después de ésta, aproximadamente se enfermó demasiado. En un principio el dictamen médico era de la tromboflebitis, luego le hicieron las pruebas de sangre en las cuales salió positivo para el estafilococo, y ya el dictamen médico era que tenía osteomielitis. Mi inquietud es si esta bacteria, la cual creemos la adquirió durante la intervención quirúrgica para tener a su bebé, es la causante de que ella termina con un dictamen médico de osteomielitis, la cual la dejó en muy malas condiciones para la movilidad (aunque puede caminar), un pie le quedó más corto que el otro, mantiene mucho dolor, tiene la cadera muy deteriorada al punto de que en este momento se está mirando la posibilidad de un trasplante de cadera. La otra inquietud es hasta qué punto hay responsabilidad de la institución que la atendía en ese momento, teniendo en cuenta que ella ya llegó allí en embarazo y con una tromboflebitis, o sea que llegó en condiciones delicadas.Sólo la tromboflebitis pudo causarle la osteomielitis o no ? O realmente fue esta feroz bacteria la que le causó la osteomielitis? Les agradecería cualquier comentario al respecto.
Gladys Roldán Pérez
Hola,
gracias por el interés, pero como se advierte en el foro, ni somos un consultorio médico ni estamos autorizados para dar este tipo de contestación. La recomendación es que consultes a tu médico de cabecera que es el profesional formado y autorizado para tratar estos casos.
Un saludo
Miguel Vicente
Bueno, y digo yo que si es una bacteria Gram +, casi seguro que se puede combatir con lisozima, ¿no?
Bueno, inyecciones de lisozima y tomar algo que estimule el sistema de complemento como el propóleo además de inmunoestimulantes-antisépticos como el aloe vera, el propóleo mismo, el ajo y la cebolla crudos, el tomillo, la equinácea, el eucalipto, la manzanilla, etcétera.
La mayoría de los estafilococos son resistentes a la lisozima. En los laboratorios, para lisarlos (romperlos) se utiliza lisostafina. Tanto la utilización de lisostafina (que es una proteína no humana), como la utilización de lisozima no humana, induciría una respuesta inmune que inactivaría las enzimas en inyecciones posteriores. Además, no creo que ninguna de las dos estuviese libre de efectos secundarios múltiples.
En cuanto a los inmunoestimulantes que propones, sinceramente, no creo que sirvan de mucho. Cuando el sistema inmune funciona bien (casi siempre) no necesita estimulantes. Cuando un microorganismo ha conseguido sobrepasar todas las barreras y producir una infección, estimular aquello que, por la razón que sea, no ha funcionado bien, no suele ser suficiente.
Buenos dias.a mi me detectaron S.aereus en la septima operacion de columna(tenia escoliosis severa) y tenia alojada la infeccion en la parte cervical.me mandaron a tomar tetraciclina cada 6 horas durante 5 semanas y ya me siento muy debil,despues de tomarlas hace 15 dias,usted cree que si continuo con el tratamiento me curare ,y no tendre ningun peligro.y si dejo el tratamiento por la fatiga que me da,cuales seran las consecuencias..y muchas cracias.
Hola,
como moderador del foro vuelvo a recordar que la política del mismo es no debatir, contestar ni reproducir los comentarios que se refieran a casos clínicos particulares, los que recomienden la automedicación o que por su contenido puedan conducir a ella. El foro no es un consultorio clínico, y lo único que podemos recomendar es consultar con el médico de cabecera de cada cuál, es el único profesional cualificado y autorizado para responder a este tipo de preguntas.
A partir de ahora (6 de septiembre de 2009) todas estas preguntas o bien se borrarán, si no añaden nada de interés general desde el punto de vista científico o docente, o serán respondidas con el siguiente mensaje:
"Para obtener respuesta a tu comentario o pregunta, por favor, acude a tu médico"
Espero que se entienda que esta respuesta es la única que podemos dar y que lo hacemos desde el mayor respeto a quienes preguntan, ya que todos entendemos que cualquier menoscabo en la salud propia o de un allegado suele producir la comprensible angustia.
Salud
Miguel Vicente
soy veterinario y el problema con el S.AUREUS es su poder de esconderse y comportarse como parásito intracelular temporal evadiendo la antibioticoterapia y la respuesta inmune sucede lo mismo en los seres humanos
Stafilococo y estreptococo es la misma infección?
Gracias
Hola Vanesa,
comprenderás que si fuese lo mismo no tendrían nombre diferente.
Sobre Streptococcus puedes leer
http://weblogs.madrimasd.org/microbiologia/archive/2009/08/24/123595.aspx
http://weblogs.madrimasd.org/microbiologia/archive/2008/06/23/95314.aspx
Saludos
Miguel
es super sabr de una palabra no muy comun asy q ls agradsko su ayuda y por abr puesto esta imformasion okiiZzzz…
El informe esta casi completo,me gustaría conocer de donde provienen los estafilococos,y ke enfermedades produce estictamente,por lo demás esta interesante el artículo,gracias.
Jseús… ¿Resistente a la lisozima, también?
:-O
Entonces tiene bastantes papeletas para matar a los neutrófilos y alimentarse de ellos, aunque obviamente hay otras proteínas además de los radicales de oxígeno, óxidos de nitrógeno y la «lejía» que producen esos leucocitos.
:-S
Ah, con respecto a lo que decía en el otro mensaje, no sólo son inmunoestimulantes, sino sobre todo microbicidas: casi todos son antivirales, bactericidas y demás, incluso fungicidas; de hecho, por resfriados con más de dos semanas con fiebre las uso, y ahora no me duran cinco días, y el aloe cura las infecciones de uñas a veces con una sola aplicación.
Era por poner casos curiosos. Se investigan las selvas y los mares, pero lo que tenemos más a mano no se oye que se investigue tanto, y he leído en MedLine que incluso, por ejemplo, para impedir la replicación del VIH sirve el propóleo:http://www.propoleo.cl/cientificospropolis/MEDLINE_HIV_PROPOLEOS.htm.
NO ES NECESARIO QUE SEAN TAN GROSEROS EN SUS RESPUESTAS Y DESPOTAS BUUU HORRIBLE FORO
para Lilia Na Huerta
hola Lilia, lamento tu reacción, que aparte de no compartir, no comprendo.
Podrías quizás considerar que el mal uso y el abuso de los antibióticos, en el que la automedicación juega un papel relevante, nos ha conducido a la situación actual en la que hay patógenos resistentes a prácticamente cualquiera de los antimicrobianos de los que disponemos.
http://www.madrimasd.org/blogs/microbiologia/2010/12/20/131213
Es por eso que como moderador intento no publicitar prácticas que a mi entender son peligrosas, no solo para el individuo, sino para la sociedad.
Por otra parte, las respuestas que se han dado me parece que se han redactado con un respeto exquisito para los comentaristas, por lo que tu comentario me parece algo exagerado.
Un saludo
Miguel Vicente
emm ojala y pueda responder la pregunta; le tengo una duda… es entendible que los medicamentos son dados por los medicos y bien se describen varios en el texto, mas mi duda es: ¿en qué ambiente o que factores de la vida cotidiana podrian influir a que se siga cultivando el estafilococo en el organismo? muchas gracias
Hola Jorge,
Staphylococcus, como se dice en el artículo es un microbio que normalmente se encuentra en la piel, la boca, las fosas nasales y la faringe. Ya sabes que en el conjunto del cuerpo humano sano llevamos nueve microbios por cada una de nuestras células. Hay una gran diversidad de microbios que habitan en nuestro cuerpo, y esta diversidad garantiza que ningún tipo de ellos predomina sobre los otros. La diferencia con el momento en el que los estafilococos se convierten en un peligro es que en esos casos estos microbios se desplazan, por heridas o porque las defensas naturales del cuerpo se debilitan, a lugares del cuerpo donde normalmente no viven, o bien aumenta su número con relación a otros tipos de microbio.
Otra propiedad que hace más peligrosos a los estafilococos de los que trata el artículo es que son variantes que han adquirido resistencias a varios antibióticos, lo que complica el tratamiento.
Permite que para obtener una visión general sobre todo esto te recomiende leer el libro «Ni contigo ni sin tí» que hemos publicado y cuya referencia es:
–
Ni contigo ni sin tí: guía para entender los microbios.
Autores: Miguel Vicente, Marta García-Ovalle y Javier Medina.
Publicado por grand guignol ediciones. ISBN: 978-84-936874-2-7
–
Un saludo
Miguel
ME GUSTARIA SABER SI AL HABER SUFRIDO YA DE ESTAFILOCOCO DORADO EN AÑOS ANTERIORES, ¿ES POSIBLE QUE SUFRA DE SECUELAS A NIVEL NEUROLOGICO?. LO SUFRI HACE YA 22 AÑOS.
Nesecito ayuda tuve estafilococo ase 7 años pero ase como un mes las mismas partes donde me salio el estafilococo ya volvieron me lo controlaron con cortizona y esteroides tengo q volver a usar la misma medicina los pequenos granitos ya estan volviendo a hacerse rojos y grandes ayuda por favooorrr
Si trata de usar la misma medicina el estafilococo siempre estara en tu cuerpo todos nosotros los humanos los tenemos
NO TE PREOCUPES SI YA TE LO CONTROLARON ASE 7 AÑOS PUEDE Q LA MEDICINA SEA LA MISMA ANIMO TE VAS A ALIVIAR NO TE ESTRESES Y ADELANTE SIEMPRE DIOS ES PRIMERO PIDELE EL TE AYUDARA
[…] Recomendada lectura de MadridMas – El estafilococo feroz […]